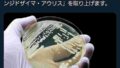

1 名前:一般よりも上級の名無しさん 投稿日時:2025/11/01(土) 00:52:05.99 ID:qz8K1rxT0
ロサンゼルスは高層ビル群がショボいらしい
シカゴはロスより経済規模は小さいけど高層ビル群が発達してるってシカゴが凄い都会すぎて東京人は驚いたね~思い描くアメリカってシカゴだった!
https://www.kemu-no-tabi.info/entry/2022/07/13/212455
2 名前:一般よりも上級の名無しさん 投稿日時:2025/11/01(土) 00:55:38.73 ID:FICAopsn0
ダークナイトの街並みだよな
なんか無機質なイメージがある
なんか無機質なイメージがある
4 名前:一般よりも上級の名無しさん 投稿日時:2025/11/01(土) 01:01:46.04 ID:M8M15hbBa
「素直になれなくて(Hard to Say I’m Sorry)」だけの一発屋
5 名前:一般よりも上級の名無しさん 投稿日時:2025/11/01(土) 01:03:39.07 ID:Du4KYrO70
歴史的な建造物も残してるからね
一方、周回遅れの田舎者中国人はギラギラの高層ビルの街が最高だとはしゃいでいたw
一方、周回遅れの田舎者中国人はギラギラの高層ビルの街が最高だとはしゃいでいたw
6 名前:一般よりも上級の名無しさん 投稿日時:2025/11/01(土) 01:03:40.31 ID:KQltaGXv0
福岡の方が名古屋よりも都会っぽく見えるみたいな話か?
7 名前:一般よりも上級の名無しさん 投稿日時:2025/11/01(土) 01:04:14.60 ID:ibv28jhG0
ロサンゼルスは土地が余ってるしむっちゃ温暖なので寄り集まって住むメリットが少ない
欧米はジャップと違って寒い地域は合理的に温かい集合住宅を好むからな
北の方ほどビルが大きい
欧米はジャップと違って寒い地域は合理的に温かい集合住宅を好むからな
北の方ほどビルが大きい
8 名前:一般よりも上級の名無しさん 投稿日時:2025/11/01(土) 01:04:46.06 ID:gABJsmQu0
ダウンタウンの都会度は圧倒的にシカゴ>LA
というかLAのダウンタウンが都市規模に比べて圧倒的にショボい
シカゴどころかSF、シアトル、マイアミ辺りもLAよりダウンタウン立派
というかLAのダウンタウンが都市規模に比べて圧倒的にショボい
シカゴどころかSF、シアトル、マイアミ辺りもLAよりダウンタウン立派
28 名前:一般よりも上級の名無しさん 投稿日時:2025/11/01(土) 01:55:33.75 ID:n7dtH7AX0
>>8
ダウンタウンは、貧乏人が遊ぶ場所。
ダウンタウンは、貧乏人が遊ぶ場所。
9 名前:一般よりも上級の名無しさん 投稿日時:2025/11/01(土) 01:04:56.42 ID:Sys4RgfC0
冬はバスを逃したらヤバい
10 名前:一般よりも上級の名無しさん 投稿日時:2025/11/01(土) 01:05:18.97 ID:p4jyxu0v0
服にフェンタニル付けられるから行くなよ
12 名前:一般よりも上級の名無しさん 投稿日時:2025/11/01(土) 01:15:52.54 ID:gVTIKU0D0
冬に凍てつく嵐が吹きあれるシカゴが都会とな?
13 名前:一般よりも上級の名無しさん 投稿日時:2025/11/01(土) 01:18:45.60 ID:nt0JJlOL0
いいなあアメリカ
金はあるけど前科あるから行けないの辛い
金はあるけど前科あるから行けないの辛い
14 名前:一般よりも上級の名無しさん 投稿日時:2025/11/01(土) 01:20:42.12 ID:zF1V67740
>>13
何の前科?
何の前科?
17 名前:一般よりも上級の名無しさん 投稿日時:2025/11/01(土) 01:23:13.13 ID:nt0JJlOL0
>>14
面会要求罪
行政書士に相談したら未成年に対する犯罪だと未来永劫アメリカ渡航不可能って言われたから生まれ変わらない限り無理
面会要求罪
行政書士に相談したら未成年に対する犯罪だと未来永劫アメリカ渡航不可能って言われたから生まれ変わらない限り無理
19 名前:一般よりも上級の名無しさん 投稿日時:2025/11/01(土) 01:24:32.50 ID:dDQfqAVU0
>>17
パパ活したのか
パパ活したのか
20 名前:一般よりも上級の名無しさん 投稿日時:2025/11/01(土) 01:31:11.06 ID:NogYZ5UZ0
>>17
どういう経緯でそんなの喰らったの?
どういう経緯でそんなの喰らったの?
22 名前:一般よりも上級の名無しさん 投稿日時:2025/11/01(土) 01:33:46.12 ID:ARgjlw2Td
>>17
自業自得じゃん
15 名前:一般よりも上級の名無しさん 投稿日時:2025/11/01(土) 01:21:27.01 ID:c+RyUm2N0
シカゴは経由で飛行機乗り換えでよく使うけど一度も降りた事無い
空港の喫煙所の位置だけは詳しい
ロスはゾーニングで高さ制限あるエリアが多い
空港の喫煙所の位置だけは詳しい
ロスはゾーニングで高さ制限あるエリアが多い
16 名前:一般よりも上級の名無しさん 投稿日時:2025/11/01(土) 01:21:53.48 ID:+Ul0WoSs0
高層ビルの数だけで都会とか判断してる時点で浅いよな
文化とか経済規模とか色々あるだろ
文化とか経済規模とか色々あるだろ
18 名前:一般よりも上級の名無しさん 投稿日時:2025/11/01(土) 01:23:43.42 ID:dDQfqAVU0
ソフマップだろ?
23 名前:一般よりも上級の名無しさん 投稿日時:2025/11/01(土) 01:45:26.00 ID:6b9OhTcn0
カブスの見てたけど大都会…ではないな(´(ェ)`)
24 名前:一般よりも上級の名無しさん 投稿日時:2025/11/01(土) 01:46:21.49 ID:n7dtH7AX0
>>1
過去の栄光
過去の栄光
25 名前:一般よりも上級の名無しさん 投稿日時:2025/11/01(土) 01:54:03.44 ID:XQDgrBrp0
鹿の子っていうと遷都的に京都か?
アイツら無駄にプライド高いからそういう煽りはキレるんじゃね?
アイツら無駄にプライド高いからそういう煽りはキレるんじゃね?
27 名前:一般よりも上級の名無しさん 投稿日時:2025/11/01(土) 01:55:02.42 ID:4UUSgdEd0
ビルの高さで発展とか中国みたいな土人じゃないんだから
29 名前:一般よりも上級の名無しさん 投稿日時:2025/11/01(土) 01:56:35.86 ID:+UxZBFA40
ウォッチドッグスのイメージ
30 名前:一般よりも上級の名無しさん 投稿日時:2025/11/01(土) 02:26:55.73 ID:JTKsHwe4H
昔の映画ではシカゴは左遷扱いだったぞ

コメント一覧